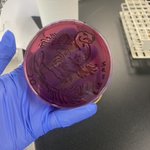

- 107 following
- 133 followers
- Follow
Not any dinosaur in particular I just wanted to draw a guy with a comb lmao #paleoart #dinosaur #dinosaurart #ArtistOnTwitter
Another commission for @witchylemon !! Sweetest person ever to work with, thank you for your support :’D #commission #ArtistOnTwitter
Commission for @witchylemon ! all the floof was so dreamy to draw #commission #digitalart #ArtistOnTwitter
Little meatbaby doodle bc such a cute lil relaxing design,, @meatflavors #digitalart #ArtistOnTwitter
She was my very first character I got from standard banner nd she’s been on the team since :’’3 #genshinimpact #genshinimpactfanart #diona
cries in razor main.,. electro buff for my bby when,..,. #razorgenshinimpact #GenshinImpact #genshinimpactfanart
Redraw of that one scene, plus a wip screenshot to appreciate da freckles more #tartaglia #GenshinImpact #genshinimpactfanart
正しいカテゴリを運営へ報告する
このツイートに主として含まれるのは、【***】ではなく、以下の画像です。
- 一般向けのイラストおよびマンガ。造形物に描かれた平面のイラスト等もここに含みます。
- コスチューム・プレイ(仮装)をした人物の写真。衣装のみの写真も含む。
- 立体造形物全般。模型・フィギュア・プラモデル・ドール・ぬいぐるみ・キャラ弁・ハンドクラフト等
- 【イラスト・マンガ】のうち、センシティブな内容(アダルト表現・グロテスク表現)を含むもの。
- 風景写真・ゲームやTVのキャプチャ・スクリーンショット・文字のみの画像等、上記にあてはまらないもの。

This site is protected by reCAPTCHA and the GooglePrivacy Policy and Terms of Service apply.
正しいカテゴリを運営へ報告する
報告ありがとうございました!
内容を確認のうえ、対応いたします。